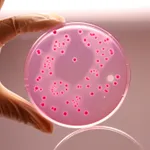
Himedia Violet Red Bile Glucose Agar w/o Lactose

Himedia RS Medium Base
✨AI 추천 연관 상품
AI가 분석한 이 상품과 연관된 추천 상품들을 확인해보세요
연관 상품을 찾고 있습니다...
RS Medium Base is used for selective isolation, cultivation and presumptive identification of Aeromonas hydrophila from clinical and non-clinical samples.It is used for selective isolation and presumptive identification of Aeromonas hydrophila and other gram-negative bacteria based on their ability to decarboxylate lysine and ornithine, maltose fermentation and H2S production. Yeast extract acts as a source of nutrients. Sodium thiosulphate, L-cysteine hydrochloride and ferric ammonium citrate are the indicators of H2S production. Maltose is fermentable carbohydrate source. Bromothymol blue is the pH indicator. Sodium deoxycholate and novobiocin inhibit gram-positive bacteria and Vibrio species. Aeromonas hydrophila show yellow coloured colonies due to maltose fermentation, Lysine and ornithine decarboxylation negative and do not produce H2S.
| Product Name | RS Medium Base |
| SKU | M576 |
| Customized Product Available | No |
배송/결제/교환/반품 안내
배송 정보
| 기본 배송비 |
| 교환/반품 배송비 |
|
|---|---|---|---|
| 착불 배송비 |
| ||
| 교환/반품 배송비 |
| ||
결제 및 환불 안내
| 결제수단 |
|
|---|---|
| 취소 |
|
| 반품 |
|
| 환급 |
|
교환 및 반품 접수
| 교환 및 반품 접수 기한 |
|
|---|---|
| 교환 및 반품 접수가 가능한 경우 |
|
| 교환 및 반품 접수가 불가능한 경우 |
|
교환 및 반품 신청
| 교환 절차 |
|
|---|---|
| 반품 절차 |
|